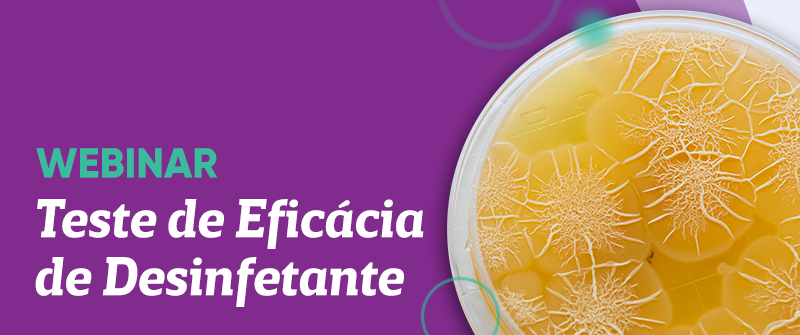

Dia Nacional de Combate a Tuberculose

Hoje (17/11) é realizado o Dia Nacional de Combate à Tuberculose. Anualmente, segundo o Ministério da Saúde, a tuberculose atinge cerca de dez milhões de pessoas no mundo, levando mais de um milhão de pacientes a óbito.
Plastlabor 33 anos

Em 2020, a Plastlabor completa 33 anos de fundação
Webinar: Validação de Métodos de Monitoramento Ambiental

Confira os conteúdos do Webinar: Validação de Métodos de Monitoramento Ambiental
Antecipação de Pedidos

Em função das festividades de fim de ano, a Plastlabor entrará em recesso e férias coletivas a partir do dia 21/12/2020.
Estudo de transporte para Meios de Cultura

A Plastlabor informa a conclusão dos novos estudos de transporte para Meios de Cultura, visando minimizar a possibilidade de água de condensação.
Webinar: Teste de Eficácia de Desinfetante
[vc_row][vc_column][vc_column_text]A Plastlabor dispobilizou os conteúdos (vídeo, apresentação e Q&A) do Webinar: Eficácia de Sanitizantes, ministrado por Vitório Santos Junior, Ph.D. Confira abaixo o material.[/vc_column_text][/vc_column][/vc_row][vc_row][vc_column][vc_wp_text][embedyt] https://www.youtube.com/watch?v=XGgYis_nQLo[/embedyt][/vc_wp_text][/vc_column][/vc_row][vc_row][vc_column][vc_column_text] Apresentação de Vitório Santos Junior: [pdf-embedder url=”https://plastlabor.com.br/wp-content/uploads/2020/10/EFICÁCIA_DE_DESINFETANTES_-_Apresentação_Plastlabor_-_Vitorio_Santos_V2.pdf” title=”Webinar: Teste de Eficácia de Desinfetante”][/vc_column_text][/vc_column][/vc_row][vc_row][vc_column][vc_column_text]INCQS é uma tradução do AOAC? Não é uma tradução. São órgão que tem atividades semelhantes, porém o […]
Dia Mundial da Sepse

O Dia Mundial da Sepse tem como objetivo conscientizar e ampliar o debate sobre esse tipo de infecção, responsável por milhares de mortes anualmente.
Produtos de sangue animal como ferramenta da microbiologia

Os produtos de origem animal ainda são essenciais para testes clínicos, mas você sabe como são produzidos?
Existe economia em cultura in house?

As soluções econômicas tornaram-se um interesse crescente para muitas empresas, que buscam métodos inovadores e convenientes para reduzir custos, aumentar a produtividade e receita, porém mantendo sempre a qualidade dos seus produtos.
Higienização Ambiental

Atualmente, ter e manter um ambiente limpo é essencial para empresas ou comércio terem capacidade de seguir em pleno funcionamento. Porém, existem diferentes produtos que podem ser utilizados para limpeza e desinfecção dos espaços.
Microbiologia no setor de cosméticos

A indústria de cosméticos produz anualmente uma grande diversidade de produtos e tem uma extensa legislação que abrange toda cadeia produtiva. A RDC nº 48/2013, da Agência Nacional de Vigilância Sanitária (ANVISA), também conhecida como a Lei das Boas Práticas de Fabricação e a Análise Microbiológica em Cosméticos, afirma “que os produtos de higiene pessoal, cosméticos e perfumes devem ser seguros nas condições normais ou previsíveis de uso”.
Controle de qualidade na indústria no pós pandemia

Com a flexibilização das regras da quarentena em muitas cidades, empresas dos mais variados segmentos, que estiveram fechadas ou funcionando parcialmente vão voltar as atividades, mas deverão se adaptar rapidamente para conseguir voltar a produção sem riscos de surtos de coronavírus entre os colaboradores. Segundo relatório da The Food Industry Association (FMI) uma das principais […]